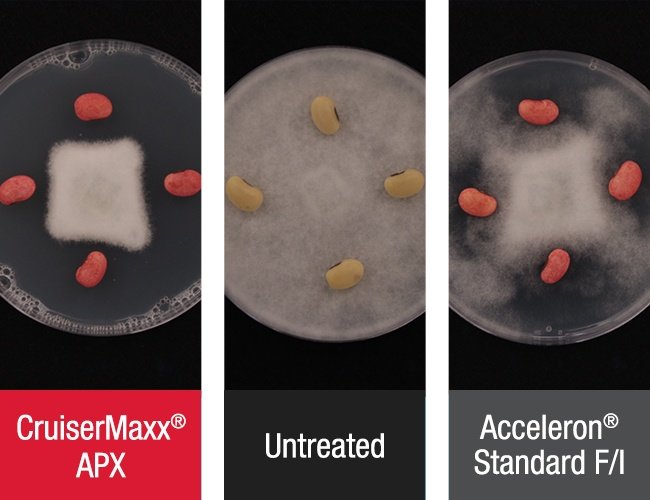

39 acceleron standard label
100113J3-5 Specimen Label.indd - Greenbook.net Jan 3, 2012 ... Have a product container or label with you when calling a ... statements on bags containing seeds treated with Acceleron® IX-409. › doi › fullLuspatercept in Patients with Lower-Risk Myelodysplastic ... Acceleron Pharma collaborates with Celgene in the development of luspatercept for the treatment of chronic anemia in patients with myelodysplastic syndromes. ... The mean values and standard ...
Acceleron® | SeedGrowth - Bayer Combining our outstanding expertise in seeds as well as crop protection into one package, Acceleron solutions give you the confidence and peace of mind of benefiting from Bayer's high-quality seed treated with the optimal product combination, protecting and promoting plant health and resilience from day one.
Acceleron standard label
Standard Performance, Dependability, and Control | Acceleron - WinField ... Standard Performance, Dependability, and Control | Acceleron - WinField® United Other products in this Category Please match the EPA No. to the product label. Consists of four fungicides for broad-spectrum disease protection plus a high rate of thiamethoxam insecticide for control of harmful insects. Warden ® Cereals WRII Seed Treatment Acceleron Presents Interim Results from the Open-label Extension of the ... Acceleron Pharma Inc. (NASDAQ:XLRN), a biopharmaceutical company dedicated to the discovery, development, and commercialization of TGF-beta superfamil Acceleron® Soybean Seed Treatment | Crop Science US - Bayer Protection against Pythium, early season Phytophthora, Rhizoctonia solani and Fusarium with an exclusive combination of fungicides and more rapid and increased emergence of seedlings under certain cold conditions. Insecticides Protection from pests including bean leaf beetles, early season soybean aphids and seedcorn maggots. Fungicides
Acceleron standard label. CAUTION - CDMS.net seed treatments using fully-automated and closed standard slurry or mist-type ... treated with Acceleron® NemaStrike™ ST must be labeled with the following ... MON 102133 SC Nematicide Seed Treatment - EPA May 5, 2020 ... PRIA Label Amendment – Change to Precautionary Label Statements, Container ... Acceleron® N-364 Nematicide Seed Treatment. Acceleron Announces Clinical Trial Updates, Preclinical Presentations ... Title: PULSAR Study Open-Label Extension: Interim Results from a Phase 2 Study of the Efficacy and Safety of Sotatercept When Added to Standard of Care for the Treatment of Pulmonary Arterial ... Seeds™ | Corn, Soybean & Specialty Seed for Iowa STANDARD Offering: metalaxyl, fluxapyroxad, pyraclostrobin, and imidacloprid. FOR CORN, EACH ACCELERON® SEED APPLIED SOLUTIONS OFFERING is a combination of separate individually registered products containing the active ingredients: BASIC plus Poncho®/VOTiVO® Offering for corn: metalaxyl, prothioconazole, fluoxastrobin, clothianidin ...
Acceleron® Seed Applied Solutions - Bayer Crop Science Apr 28, 2022 ... Seed Treatment Made Simple? We're On It. · Acceleron Key Benefits · Effective Against · Registered Crops · Labels / MSDS · To download Acceleron® ... PDF DX-612 dO NOT - CDMS Acceleron® dX-612 Fungicide Seed Treatment is a broad-spectrum fungicide that provides preventive seed and seedling protection from several seed and soilborne diseases. Make all applications according to the use directions in this label. Use the higher rates of ® dX-612 Acceleron Fungicide Seed Treatment whendisease pressure is expected to be ... Sotatercept for the Treatment of Pulmonary Arterial Hypertension Web홸 bars indicate standard errors. Panel B shows pulmonary vascular resistance at baseline and at the end of the placebo-controlled treatment period (week 24) in the three groups. The horizontal ... › en-us › productsHarvest Results | Channel® Seed Brand STANDARD Offering: metalaxyl, fluxapyroxad, pyraclostrobin, and imidacloprid. FOR CORN, EACH ACCELERON® SEED APPLIED SOLUTIONS OFFERING is a combination of separate individually registered products containing the active ingredients: BASIC plus Poncho®/VOTiVO® Offering for corn: metalaxyl, prothioconazole, fluoxastrobin, clothianidin ...
Pesticides - NYS Dept. of Environmental Conservation WebPesticides classified as restricted use by USEPA will have a boxed statement on the top of the label indicating they are restricted use. While pesticides restricted by DEC only, and not by USEPA, will not have this label statement. In the case of this neonicotinoid reclassification, the listed neonicotinoid pesticides are DEC restricted and will not … Acceleron Soybeans | Seed Treatment | Bayer Crop Science Canada Effective Against Diseases Controlled or Suppressed When Using Acceleron Basic Rhizoctonia Pythium Fusarium Phomopsis Phytophthora Diseases Controlled or Suppressed When Using Acceleron Standard Rhizoctonia Pythium Fusarium Phomopsis Phytophthora Insects Controlled or Suppressed When Using Acceleron Standard Bean leaf beetles Soybean aphids PDF 1. PRODUCT IDENTIFICATION Acceleron® IDL-810 Insecticide and ... - CDMS Acceleron® IDL-810 Insecticide and Fungicides Seed Treatment Version: 1.0 Effective date: August 30, 2010-524. ... Have the product container, label or Material Safety Data Sheet with you when calling ( , a poison contol center or doctor, or going for treatment. If swallowed: Call ( , a poison control center or doctor immediately for treatment ... globallegalchronicle.comGlobal Legal Chronicle – Global Legal Chronicle Dec 14, 2015 · Cooley advised 645 Ventures on the deal. 645 Ventures, an early-stage venture capital firm, announced the formation of its oversubscribed fourth fund, 645 Ventures IV, and...
Acceleron Portfolio | Stone Seed™ Acceleron® Seed Applied Solutions Crop Coverage on Four Fronts With one decision, you can protect your seeds from diseases, insects, nematodes, as well as moisture or nutrient stress. Acceleron® portfolio makes it easy to give your seeds the coverage they need to rise out of the ground, strong, healthy and ready for just about anything. Fungicides
Determining Soybean Seeding Rates | Channel® Seed FOR SOYBEANS SEED TREATMENT PRODUCTS APPLIED DOWNSTREAM, EACH ACCELERON® SEED APPLIED SOLUTIONS OFFERING is a combination of separate individually registered products containing the active ingredients: BASIC Offering: metalaxyl, penflufen and prothioconazole. STANDARD Offering: metalaxyl, penflufen, prothioconazol and imidacloprid.
PDF Safety Data Sheet Acceleron I-609 - download.basf.com Product identifier used on the label Acceleron I-609 Recommended use of the chemical and restriction on use Recommended use*: crop protection product, insecticide ... According to Regulation 2012 OSHA Hazard Communication Standard; 29 CFR Part 1910.1200 Classification of the product Acute Tox. 4 (oral) Acute toxicity Acute Tox. 4 (Inhalation ...
Glioma | Nature Reviews Disease Primers Web16/07/2015 · Gliomas are primary brain tumours that are thought to derive from neuroglial stem or progenitor cells. On the basis of their histological appearance, they have been traditionally classified as ...
Global Legal Chronicle – Global Legal Chronicle Web13/12/2022 · Cooley advised Avant on the deal. Avant, a credit-first financial technology company, announced that it secured $250 million of corporate debt and redeemable preferred equity from...
traits.bayer.com › corn › PagesSmart Corn System | Bayer Traits Target ear height will be ≥ 2 feet to maintain compatibility with standard harvest equipment. Ear size is similar to that of current corn hybrids. Due to improved plant standability, they will allow farmers to explore higher planting densities, providing the potential to produce more on every acre.
PDF ATTENTION - Amazon Web Services possible Acceleron DX-309 Fungicide Seed Treatment resistant strains of fungi which may occur. FAILURE TO FOLLOW DIRECTIONS ON THIS LABEL MAY RESULT IN CROP INJURY OR POOR DISEASE CONTROL. Cotton For Pythium seed rot and damping-off: Apply Acceleron DX-309 Fungicide Seed Treatment as a seed treatment at the rate of 0.75-1.5 fl oz
Acceleron DX-109 | Bayer CropScience | Agworld DBX | Greenbook Acceleron DX-109 Bayer CropScience Labels LabelSDS SnapshotID: 46149 Active ingredients Pyraclostrobin Classification 11 Fungicide WSSA mode of action complex III of fungal respiration: ubiquinol oxidase, Qo site Registration EPA:7969-266-524 Pests Damping-offSeedling Disease, PythiumSeed DecaySeedling DiseaseDamping-offSeedling DiseaseSeed Decay
Luspatercept in Patients with Lower-Risk Myelodysplastic Syndromes WebThe mean values and standard errors were not calculated if the number of patients was less than 8 in the luspatercept group of patients without a response or if the number was less than 4 in the ...
Acceleron Seed Treatments | Seed Treatment | Bayer Crop Science Canada Acceleron ® Seed Treatments Every season you face unpredictable threats. That's why you need a seed treatment that can help put you on the path to predictable results. The Acceleron ® portfolio is an advanced seed treatment solution that helps deliver more control and better protection.
Acceleron® Seed Applied Solutions | Kruger Seeds™ Acceleron® Portfolio of Products Crop Coverage on Four Fronts With one decision, you can protect your seeds from diseases, insects, nematodes, as well as moisture or nutrient stress. Acceleron® portfolio makes it easy to give your seeds the coverage they need to rise out of the ground, strong, healthy and ready for just about anything. Fungicides
Acceleron Standard Label Soybean Quick and Easy Solution Acceleron Standard Label Soybean will sometimes glitch and take you a long time to try different solutions. LoginAsk is here to help you access Acceleron Standard Label Soybean quickly and handle each specific case you encounter. Furthermore, you can find the "Troubleshooting Login Issues" section which can answer your unresolved problems ...
Harvest Results | Channel® Seed Brand WebSTANDARD Offering: metalaxyl, fluxapyroxad, pyraclostrobin, and imidacloprid. FOR CORN, EACH ACCELERON® SEED APPLIED SOLUTIONS OFFERING is a combination of separate individually registered products containing the active ingredients: BASIC plus Poncho®/VOTiVO® Offering for corn: metalaxyl, prothioconazole, fluoxastrobin, …
Standard Performance, Emergence, and Control | Acceleron - WinField® United Standard Performance, Emergence, and Control | Acceleron - WinField® United Other products in this Category Please match the EPA No. to the product label. Contains a unique combination of three fungicides to help protect against various diseases in cereal crops. Warden ® Cereals II Seed Treatment
DEKALB | Acceleron |Plant Protection Acceleron® Seed Applied Solutions ELITE with Enhanced Disease Control seamlessly added to DEKALB brand corn. Added Value With No Added Cost A history of success starts with one easy decision. DEKALB brand corn and Acceleron Seed Applied Solutions ELITE with Enhanced Disease Control protect your investment.
Channel® Seed | Customized Service, Expert Advice & Elite Seed … WebSTANDARD Offering: metalaxyl, fluxapyroxad, pyraclostrobin, and imidacloprid. FOR CORN, EACH ACCELERON® SEED APPLIED SOLUTIONS OFFERING is a combination of separate individually registered products containing the active ingredients: BASIC plus Poncho®/VOTiVO® Offering for corn: metalaxyl, prothioconazole, fluoxastrobin, …
Asgrow | Acceleron | Plant Protection - DEKALB Asgrow Deltapine Rise Stronger With One Simple Decision Choosing to protect your Asgrow® soybeans and your yield with the Acceleron® portfolio can deliver protection from diseases, insects, nematodes, as well as moisture or nutrient stress. Rise stronger with more coverage. Coverage On Four Fronts Fungicides
› en-us › harvest-plotsGold Country Seed® Plots | Gold Country Seed® STANDARD Offering: metalaxyl, fluxapyroxad, pyraclostrobin, and imidacloprid. FOR CORN, EACH ACCELERON® SEED APPLIED SOLUTIONS OFFERING is a combination of separate individually registered products containing the active ingredients: BASIC plus Poncho®/VOTiVO® Offering for corn: metalaxyl, prothioconazole, fluoxastrobin, clothianidin ...
PDF 2017 Seed Applied Solutions for Soybean - mssoy.org Acceleron® Seed Applied Solutions ELITE Individual results may vary, and performance may vary from location to location and from year to year. This result may not be an indicator of results you may obtain as local growing, soil and weather conditions may vary. Growers should evaluate data from multiple locations and years whenever possible.
2021 Acceleron Product and Application Guide - Bayer Acceleron Seed Applied Solutions STANDARD Number of seed units* to be treated Product Packaging Acceleron.Seed.Applied.Solutions . STANDARD.plus.custom. blending.service 300 2.X.2.34.gal.jugs Acceleron B-200 SAT Number of seed units* to be treated Product Packaging Case.of.2.X.1.3.gal. 15.gal.drum Acceleron E-007 SAT Number of seed units* to be ...
Acceleronlabs | Acceleron NAS ACCELERON NAS Hardware Specifications. Form factor. 2U, 19" rack mount. Dimensions (WxDxH) - 438 x 658 x 174 (mm). Processor subsystem. Intel Xeon Silver 4110, 8C, 2.1GHz, 85W. From 16GB Up to 128GB RAM (configured at purchase) Support Intel® OptaneTM DC Persistent memory. Intel® C621 chipset.
Acceleron Portfolio | Jung Seed Genetics™ With one decision, you can protect your seeds from diseases, insects, nematodes, as well as moisture or nutrient stress. Acceleron® portfolio makes it easy ...
Acceleron DC-309 | Bayer CropScience | Agworld DBX | Greenbook View the product label for Acceleron DC-309 from Bayer CropScience. See active ingredients, product application, restrictions, and more at Agworld DBX, ...
Acceleron Inc - Electron Beam (EB) Welding, Precision Laser Welding ... Over 40 years serving industries across the globe. Acceleron Inc. has been recognized as the industry's leading resource for electron beam welding (EBW) and precision laser welding services. We are a third-generation family owned business with old fashioned values, integrity, workmanship, dependability, work ethics and where a handshake ...
Corn, Soybeans, Alfalfa, Sorghum Seed Products - Channel WebSTANDARD Offering: metalaxyl, fluxapyroxad, pyraclostrobin, and imidacloprid. FOR CORN, EACH ACCELERON® SEED APPLIED SOLUTIONS OFFERING is a combination of separate individually registered products containing the active ingredients: BASIC plus Poncho®/VOTiVO® Offering for corn: metalaxyl, prothioconazole, fluoxastrobin, …
Acceleron IX-409 | Bayer CropScience | Agworld DBX | Greenbook View the product label for Acceleron IX-409 from Bayer CropScience. See active ingredients, product application, restrictions, and more at Agworld DBX, powered by Greenbook ... We're here to provide you with a reliable source of plant protection chemical label data so that you can find the information you need for managing weeds, pests and ...
Acceleron® Portfolio | Channel® Seed Brand The Acceleron® portfolio can deliver protection from yield-robbing threats, including diseases, insects, nematodes, as well as moisture or nutrient stress. Being prepared with the right protection, along with expert advice of a Seedsman, can help your crops rise out of the ground strong and ready for whatever the season has in store. Fungicides
- We help more people save through partnerships with ... Everyone deserves to feel financially secure. We help more people save through partnerships with leading financial institutions and state governments.
Ascensus - We help more people save through partnerships with … WebEveryone deserves to feel financially secure. We help more people save through partnerships with leading financial institutions and state governments.
Nivolumab plus Ipilimumab versus Sunitinib in Advanced Renal … Web21/03/2018 · Sunitinib, a vascular endothelial growth factor receptor tyrosine kinase inhibitor, is a standard of care for first-line treatment of advanced renal-cell carcinoma. 1 In a large, randomized, phase ...
Acceleron's Label Expansion, And Other News: The Good, Bad And Ugly Of ... Summary. Acceleron has been granted label expansion for luspatarcept by the FDA. Gilead's remdesivir has been granted compassionate use approval in Europe against covid-19.
Acceleron to Launch Phase 3 Trial Testing Sotatercept by Year's End Acceleron also plans to present latest data from its ongoing Phase 2 trials — PULSAR ( NCT03496207) and SPECTRA ( NCT03738150 ), evaluating sotatercept in PAH patients with moderate physical limitations — at the American Heart Association (AHA) 2020 Scientific Sessions virtual meeting, which begins today and runs through Tuesday.
Acceleron DX-109 Fungicide Seed Treatment Crop-specific Use Directions ... Acceleron is a registered trademark of Monsanto Technology, LLC. ST1108 Produced for: MONSANTO COMPANY • 800 N. Lindbergh Blvd. St. Louis, Missouri 63167 7969-266-524_Acceleron DX-109 Fungicide Seed Treatment_20171016_71_524_.pdf FIRST AID If swallowed • Call a poison control center or doctor immediately for treatment advice.
PDF SOYBEAN SEED TREATMENTS AND INOCULANTS Fungicide ... - Mississippi Soybean Labels for each listed product can be accessed by clicking on the product name. Information about rates and ... Acceleron DX-109, DX-309, DX-612 fungicides plus IX-409 [imidacloprid insecticide (4)] Intego Suite Soybeans Metalaxyl* (4), Ethaboxam* (22), and Ipconazole* (3) fungicides plus
Acceleron® Soybean Seed Treatment | Crop Science US - Bayer Protection against Pythium, early season Phytophthora, Rhizoctonia solani and Fusarium with an exclusive combination of fungicides and more rapid and increased emergence of seedlings under certain cold conditions. Insecticides Protection from pests including bean leaf beetles, early season soybean aphids and seedcorn maggots. Fungicides
Acceleron Presents Interim Results from the Open-label Extension of the ... Acceleron Pharma Inc. (NASDAQ:XLRN), a biopharmaceutical company dedicated to the discovery, development, and commercialization of TGF-beta superfamil
Standard Performance, Dependability, and Control | Acceleron - WinField ... Standard Performance, Dependability, and Control | Acceleron - WinField® United Other products in this Category Please match the EPA No. to the product label. Consists of four fungicides for broad-spectrum disease protection plus a high rate of thiamethoxam insecticide for control of harmful insects. Warden ® Cereals WRII Seed Treatment

Post a Comment for "39 acceleron standard label"